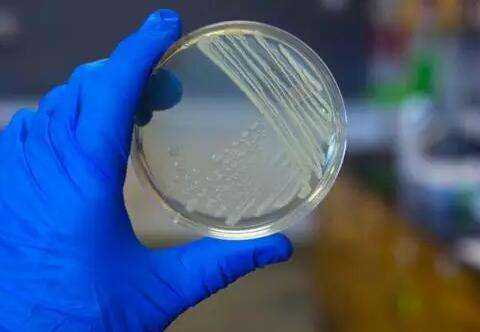

首页 > 新闻资讯 > 公司动态
助力“VIC”模式新药研发,方达医药投资千万改建上海分部实验室
助力“VIC”模式新药研发,方达医药投资千万改建上海分部实验室

2019年1月8日,三仁装饰与方达医药完成设计签约,2019年1月30日完成施工签约,并于2019年年初动工,全面开展位于军事医学科学院张江研发中心的Lab+Office装修项目。
方达医药是全方位一体化的医药研发合同研究组织(CRO),于2006年增设方达医药技术(上海)有限公司,是中国第一个按照美国FDA标准建立和运营的GLP实验室。

2019年1月18日,SAREN设计总监携方达医药EHS专员,带领项目经理、工程监理等一行人,来到方达医药技术(上海)有限公司的研发中心。
勘察大楼内全部施工现场,并充分考虑周边建筑环境形象及物料配送方案,进行了完整详细的工程处理交接。


2019年1月19日开始,SAREN方达项目组正式进场,开展原有实验室的拆除工作。
保留可利用地砖及外部形象维护,完成了彩钢板墙体拆除、玻璃隔断拆除、矿棉板和石膏板吊顶拆除、PVC地面及地板拆除、平板灯及灯具拆除。



现场工作人员着装整齐、工作认真、互相配合、听从管理。

注重区域卫生的管理,及时收集和分类整理垃圾。


2019年2月20日,SAREN方达项目组年后正式开工,开展原有实验室的拆除与一二层装修工程;实验室&办公室装饰装修工程;消防工程;强电安装工程;气体管路安装工程;系统排风工程。

建筑边角保护周到,施工地面及时清理。